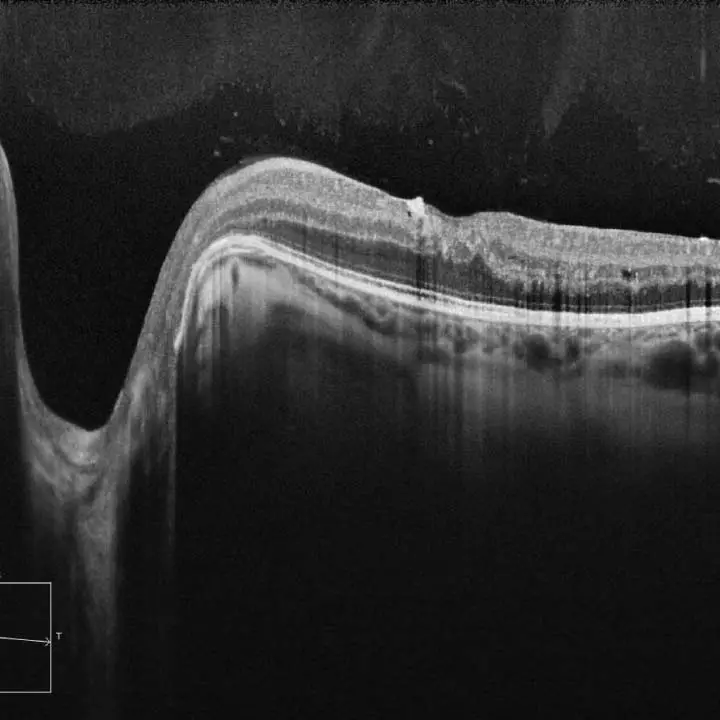

Optical Coherence Tomography (OCT) Advanced Eye Exams in Edmonton.
A common misconception is that all eye exams are created equal. Unlike big box stores and many retail-focused shops, Eye-deology Vision Care invests in the modern technologies, like Optical Coherenece Tomography (OCT), required to provide state-of-the-art comprehensive eye exams and eye care. Why is this important? Because advanced technologies, like OCT, enable our optometrists to see more and promote the early detection of eye diseases that can cause irreversible vision loss. Like how dentists use x-rays, gynecologists use ultrasounds, and neurosurgeons use an MRI, our optometrists use technologies such as OCT scans and wide-angle retinal photography to provide the best possible care to patients.
Schedule An Exam Our Optometrists
(780) 473-6123
Eye-deology Vision Care
What Is Optical Coherence Tomography (OCT)?
Optical Coherence Tomography (OCT) is a non-invasive imaging technology used to capture detailed cross-sectional images of the retina, the light-sensitive tissue at the back of the eye. Similar to an ultrasound, which uses sound waves to create images of internal organs, OCT uses light waves to produce high-resolution images of the retina and optic nerve. This advanced diagnostic tool allows our optometrists in Edmonton to observe the different layers of the retina, providing essential insights into the health of your eyes.
Schedule An OCT Eye Exam
Edmonton Eye Doctors.
Why do I Need Optical Coherence Tomography Imaging?
An OCT exam is essential for maintaining optimal eye health, especially if you are at risk for certain eye conditions. Studies have shown that using Optical Coherence Tomography along with Retinal Photography can help detect eye disease up to 10 years earlier than manual examinations. Early detection of retinal issues through OCT allows for timely intervention, which can prevent or minimize vision loss. Regular OCT exams can also monitor the progression of existing eye conditions, ensuring that treatment plans are effective and adjusted as necessary.
Schedule An OCT Test
Optometrists in Edmonton.
What Eye Diseases & Disorders Can OCT Help Diagnose?
OCT is instrumental in diagnosing and managing a variety of eye conditions. Some of the common conditions OCT can help identify include:
- OCT helps detect early signs of AMD, a condition that affects the central part of the retina, leading to vision loss.
- By imaging the optic nerve, OCT can detect changes indicative of glaucoma, a condition that causes damage to the optic nerve and can lead to blindness if untreated.
- OCT can identify the effects of diabetes on the retina, such as diabetic retinopathy, swelling, bleeding, and abnormal blood vessels.
- Macular edema is a condition characterized by the thickening of the retina due to fluid accumulation, often associated with diabetes and other conditions.
- OCT can detect the pulling of the vitreous gel on the retina, which can lead to macular holes or retinal detachment.

Advanced Eye Exams in Edmonton.
What Happens During OCT Testing?
During an OCT exam, the patient is seated comfortably in front of the OCT machine. The procedure is quick and painless, taking only a few minutes. The patient will be asked to place their chin on a rest and focus on a target. The OCT device then scans the eyes using a light source, and high-resolution images of the retina are captured. The images are immediately available for the optometrist to review, allowing for a thorough examination of the retina's structure and any potential abnormalities.
Schedule An Eye Exam
Diagnostic Imaging.
How Does OCT Differ From Retinal Photography?
While both OCT and retinal/fundus photography are valuable diagnostic tools, they serve different purposes. Retinal photography, or fundus photography, captures surface images of the retina, providing a broad view of its condition. In contrast, OCT offers detailed cross-sectional images of the retina's layers, revealing more intricate, below the surface, details that are not visible with standard retinal photography. OCT is particularly useful for detecting and monitoring conditions that affect the deeper structures of the retina and optic nerve.
Schedule An Eye Test
Edmonton Eye Care.
Why Our Edmonton Optometrists Include OCT in Every Eye Exam
At our Edmonton optometry clinic, we believe in providing the highest standard of eye care. That is why we include Optical Coherence Tomography (OCT) imaging in every child, adult, and senior eye exam . The advanced imaging technology of OCT allows our Edmonton eye doctors to detect and diagnose eye conditions at their earliest stages, even before symptoms appear. This proactive approach ensures that we can offer timely and effective treatments, preserving your vision and maintaining your eye health. By incorporating OCT into our comprehensive eye exams, we are committed to delivering thorough, modern eye care that keeps your eyes healthy and your vision clear.
Schedule An Eye Exam
OCT FAQs
Our Edmonton Optometrists
Searching for an optometrist in Edmonton? Our experienced Edmonton eye doctors use advanced modern technologies and devote upwards of 500% more time towards providing personalized patient care than elsewhere so that they can see more and ensure that you may never see less. Position yourself to see the future with a visit to our eye clinic and Edmonton's best eye care!

Dr. Jennifer Ash, OD
Dr. Jennifer Ash is the Resident Optometrist at Eye-deology Vision Care. Dr. Ash provides patient care 5 days a week. Read more about Dr. Ash.

Dr. Ruhee Kurji, OD
Dr. Ruhee Kurji is an Associate Optometrist at Eye-deology Vision Care. Dr. Kurji provides patient care Tuesdays & Fridays. Read more about Dr. Kurji.

Dr. Jade McLachlin, OD
Dr. Jade McLachlin is an Associate Optometrist at Eye-deology Vision Care. Dr. McLachlin provides patient care 5 days a week. Read more about Dr. McLachlin.

Dr. Tania Mathews, OD
Dr. Tania Mathews is an Associate Optometrist at Eye-deology Vision Care. Dr. Mathews provides patient care 2 days a week. Read more about Dr. Mathews.
Learn Why Our Edmonton Optometrists Are The Best!



